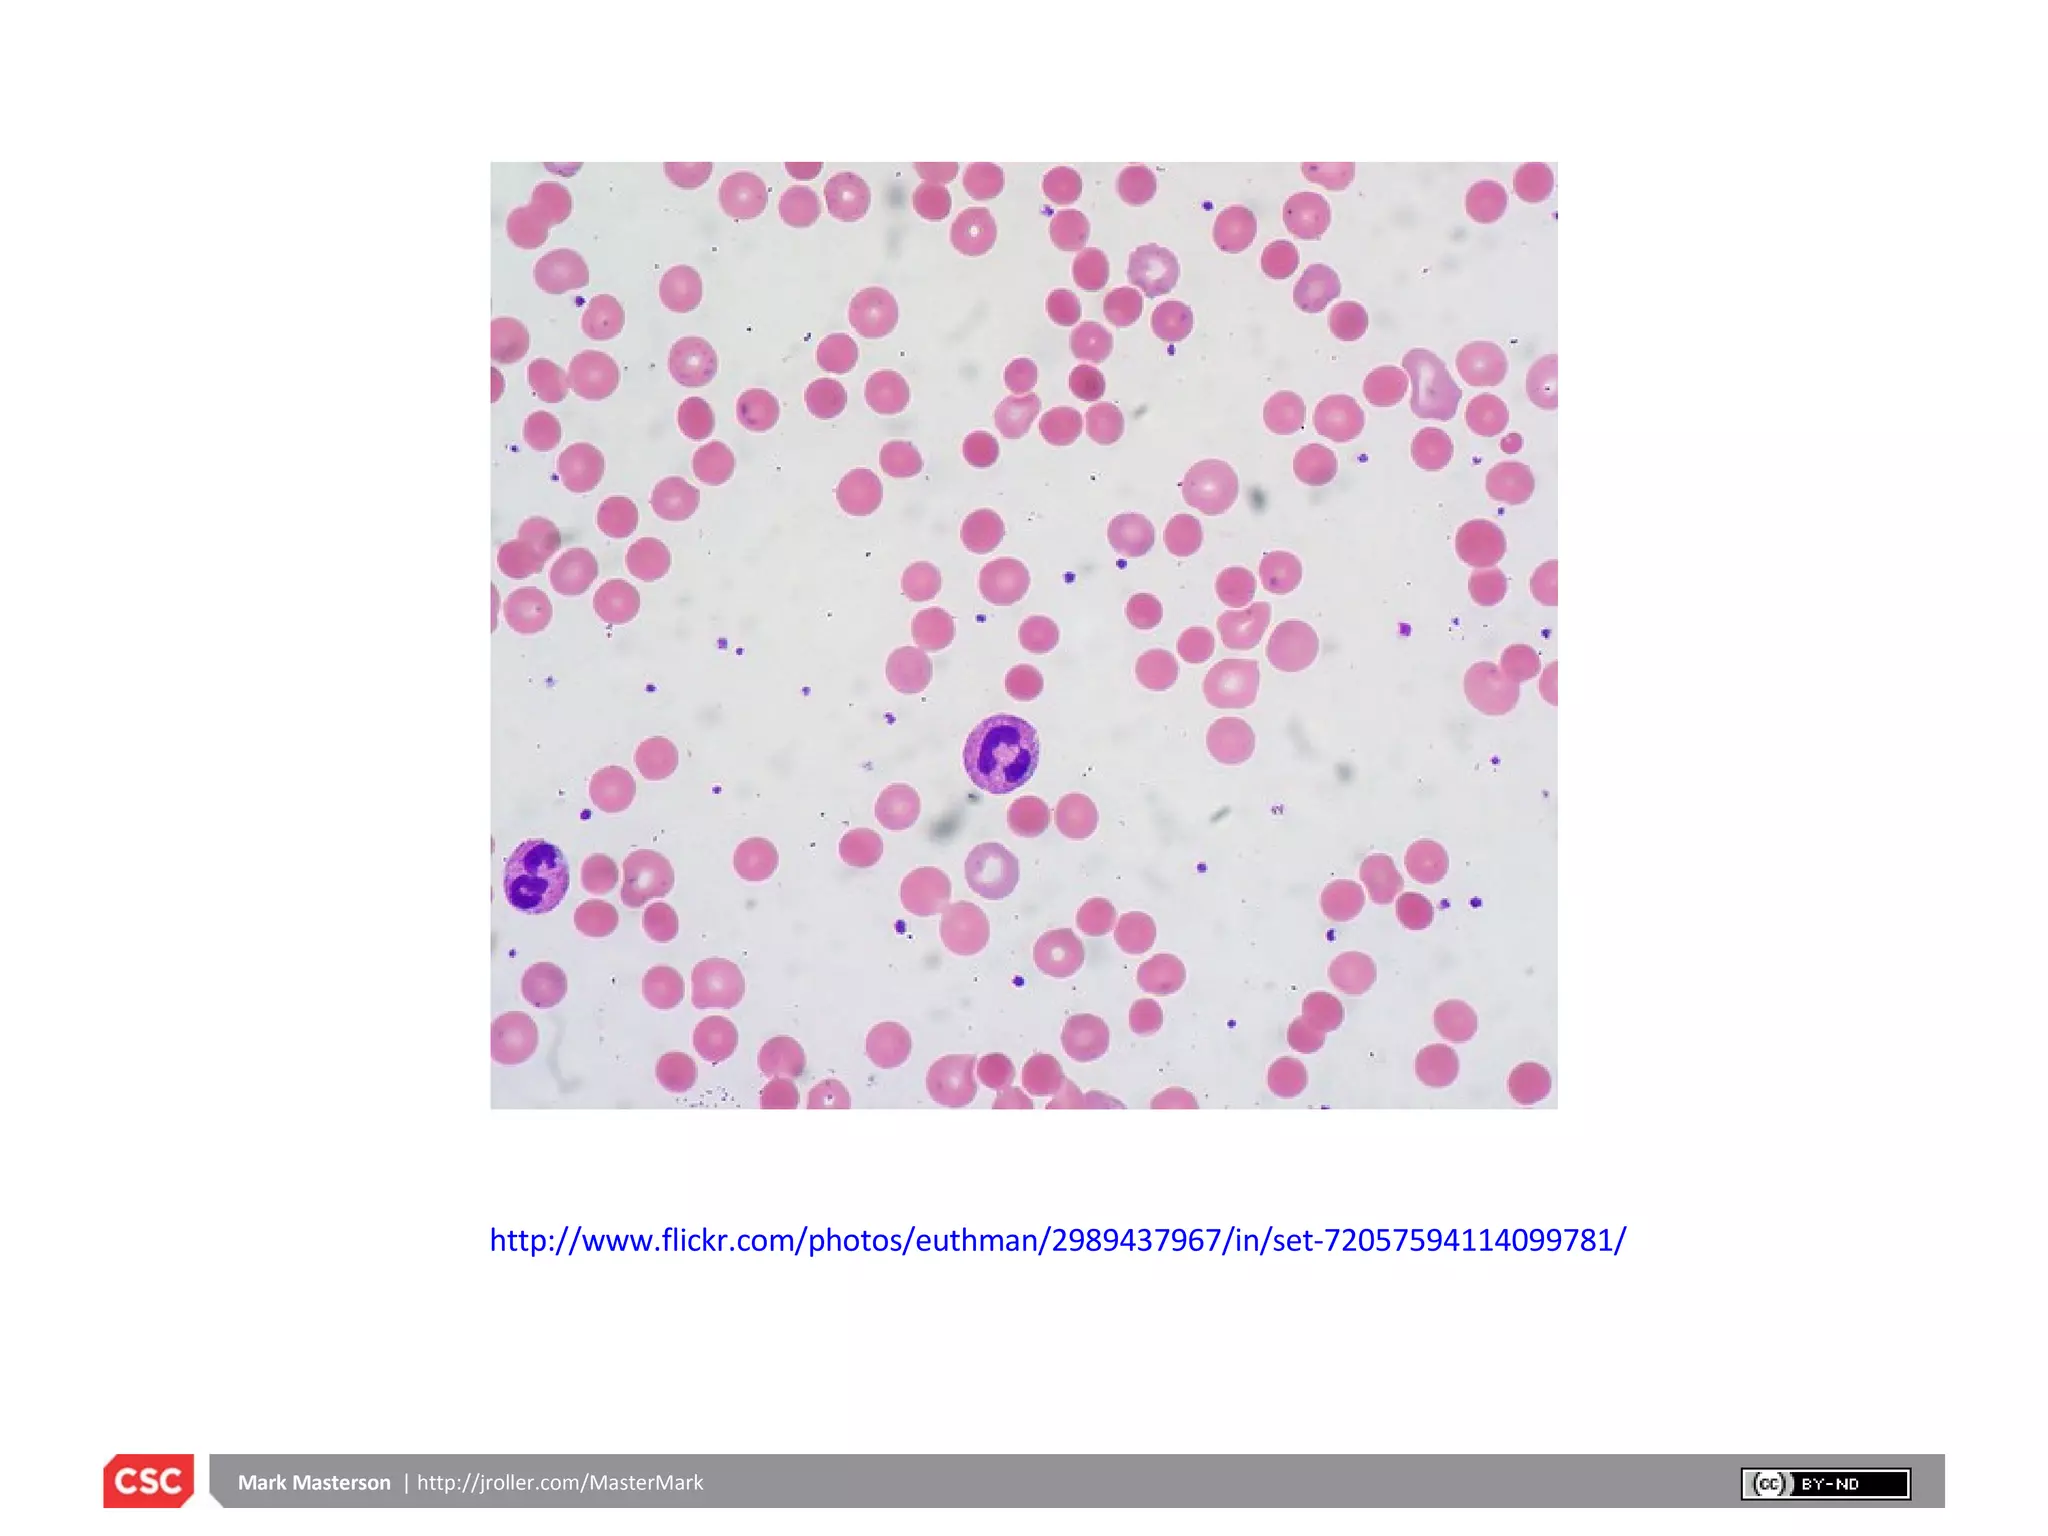
http://www.flickr.com/photos/euthman/2989437967/in/set-72057594114099781/

This document discusses key aspects of enterprise cloud computing including definitions of cloud computing, the SPI model of cloud services, and architectural choices and challenges presented by cloud computing. Some of the main challenges mentioned are the need for elastic resources, stateless and asynchronous system designs, data sharding, and ensuring redundancy and high availability despite constant failures.